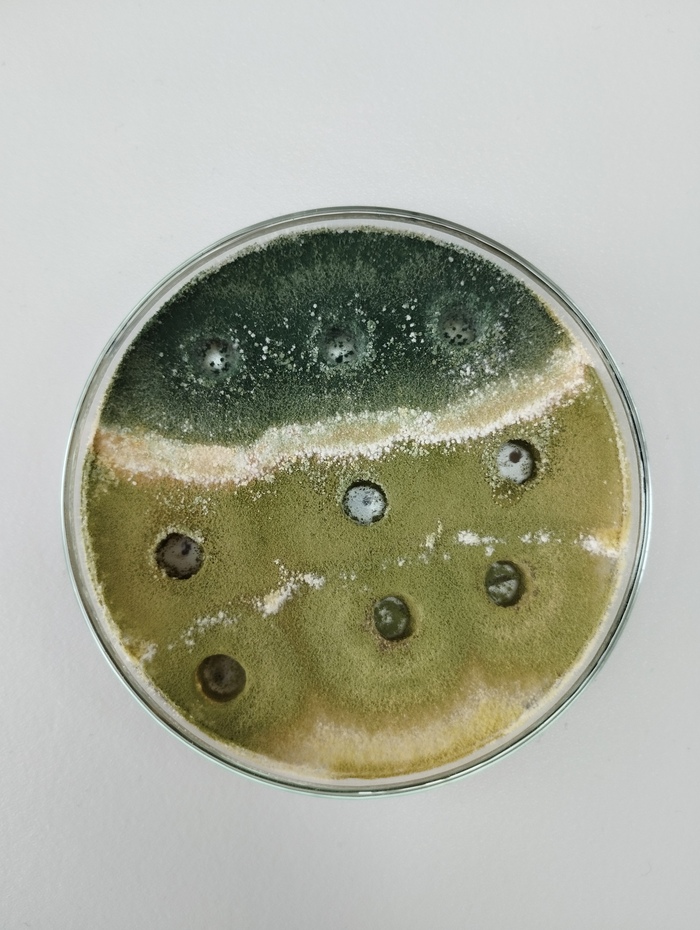

Глава КФХ Абдулаев из Ровенского района Саратовской области приобрел для своего хозяйства 80 тонные автовесы
По озвученной информации от губернатора Романа Бусаргина на совещании с членами исполнительной власти Саратовской области на 9 октября Саратовские аграрии смогли собрать 5,3 миллиона тонн зерна с 95% уборочных площадей.
Эти цифры подтверждают, что в Приволжском федеральном округе Саратовская область продолжает сохранять ведущие позиции. Полностью уборку зерновых завершили четыре района: Новоузенский, Питерский, Ершовский и Татищевский. В шести районах собрали более 200 тысяч тонн зерна: Балашовском, Пугачевском, Екатериновском, Калининском, Ершовском и Самойловском. Хлеборобы Турковского района преодолели рубеж в 100 тысяч тонн.
В настоящее время идет активная уборка подсолнечника, при этом темпы уборки превышают прошлогодний уровень и составляют 54% от клина», — говорится в сообщении.
Средняя урожайность составляет 23,3 центнера с гектара. По итогам уборочной кампании планируется собрать 5,5 миллиона тонн зерна.
На экваторе уборочной кампании Ровенский район являлся лидером по темпу уборки урожая это позволило аграриям этого региона закрепится на лидирующих позициях. Так же в этом районе Саратовской области для аграрного предприятия Завод СХТ смонтировал автомобильные весы модели ВА «СХТ» 1-80-18-3-0. Данная модель позволяет сотрудникам ГКФХ Абдулаев взвешивать практически любой грузовой транспорт с прицепом, задействованный на агропредприятии. Благодаря наличию весоизмерительного оборудования аграрии получают возможность более точно узнать о количестве принятого и отправленного сырья и продукции что помогает складу компании работать в оптимальном режиме. Так же наличие автомобильных весов на предприятии позволяет наладить логистику предприятия в том числе в значительной степени сократить на нее расходы предприятия и исключить штрафы за перегруз. Кроме того, качественное исполнение автомобильных весов исключает простои предприятия ведь автомобильные весы от Завода СХТ изготавливаются по современным ГОСТам и СНПипам, благодаря чему преждевременный выход из строя автомобильных весов сведен к абсолютному минимуму.
По желанию заказчика метрологическая служба СХТ провела успешную первичную государственную поверку весоизмерительного оборудования результат которой отмечен в технической документации весов. Положительный результат поверки позволяет без риска получения штрафа применять автомобильные весы в коммерческих целях.